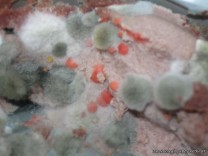

A partir de un cultivo de hongos filamentosos, antiguamente llamados “mohos”, los alumnos de 6to año, con orientación en modalidad naturales, en el espacio curricular Salud prepararon las muestras y realizaron la observación microscópica en fresco. Pudieron observar claramente el micelio de los hongos, formado por miles de hifas septadas .No todos los hongos son patógenos, los que lo son, ocasionan enfermedades fúngicas o micosis.
Las enfermedades fúngicas afectan a humanos, a animales y plantas; en estas últimas, afecta al rendimiento de los cultivos.

Seguí al colegio